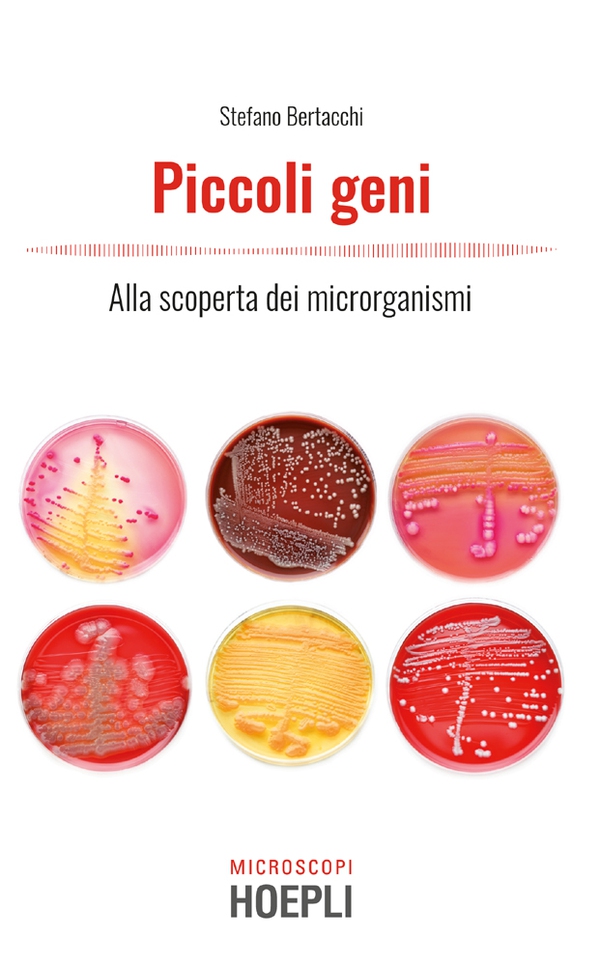

Per gli acquisti online: spese di spedizione gratuite da 25€ - Per i soci Coop o con tessera fedeltà Librerie.coop gratuite a partire da 19€.
EBOOK - epub 3
Descrizione
Un fantastico viaggio nel microcosmo, esplorando la straordinaria biodiversità microbica di batteri, lieviti e muffe, i cui nomi scientifici, a volte bizzarri e impronunciabili, nascondono incredibili caratteristiche. Dal fondo dell’oceano alle nuvole, dall’Antartide alla macchina del caffè, i microrganismi hanno colonizzato moltissimi habitat, alcuni degni dell’inferno dantesco, e sono fondamentali per la vita sulla Terra. Questi esseri si muovono, mangiano e persino cacciano, si fanno la guerra, ma allo stesso tempo collaborano tra di loro e anche con esseri viventi ben più grandi, quali noi umani ricoperti e pieni di microrganismi come siamo, letteralmente dalla testa ai piedi. Un volume che, se da un lato ci condurrà in un tour del corpo umano dalla bocca fino all’intestino, dall’altro ci porterà a capire perché la nostra società è fortemente legata a questi piccoli geni, nel male, come le malattie, ma anche nel bene, dal cibo fino alle biotecnologie, che permettono di sfruttarli per detersivi e plastiche del domani.